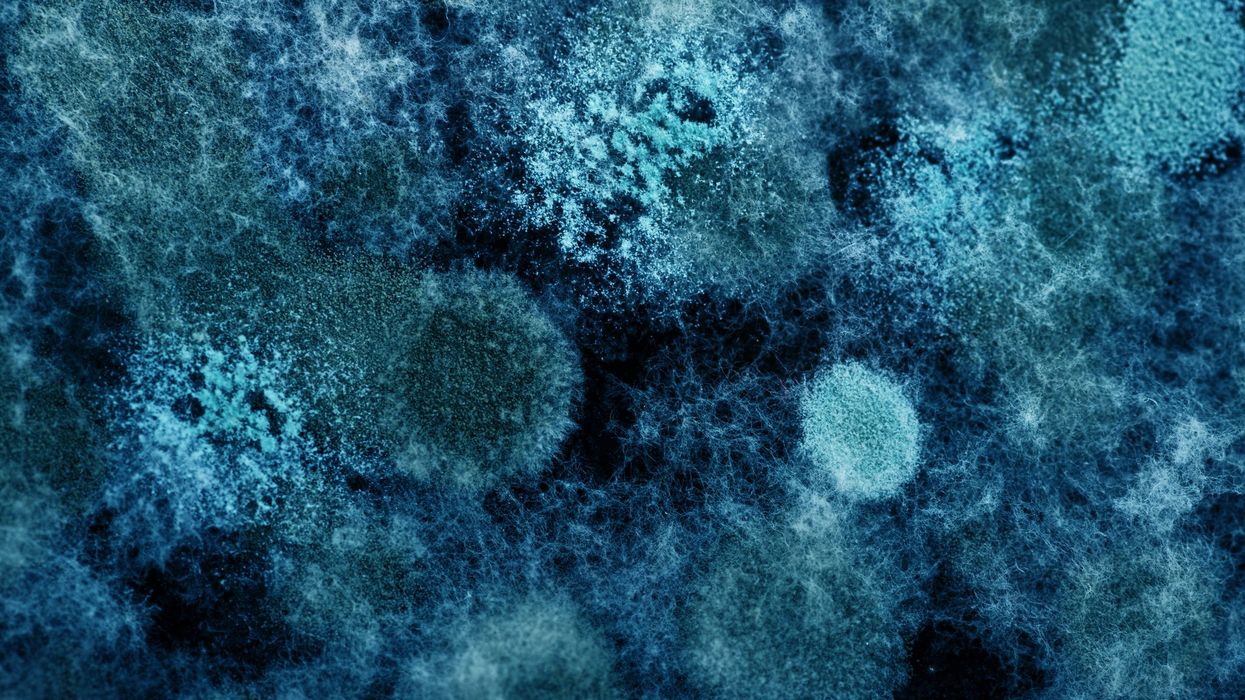

Science & Tech
Harry Fletcher
Feb 24, 2024
iStock
Scientists have discovered rare proteins that can degrade plastic, as well as bacteria that could assist in plastic biodegradation.
The significant study could have a big impact on how we tackle plastic pollution in the future.
Scientists at the University of Stirling’s Faculty of Natural Sciences are behind the new research into bacteria found living on plastic debris.
Researchers from the University of Mons in Belgium were also involved in the study, which saw proteins present in plastic samples from Gullane beach in East Lothian.
While it can take hundreds of years for plastic to degrade, the new discovery could prove to be hugely significant in future.
Dr Matallana-Surget said: “Plastic pollution has reached critical levels in the marine environment, with trillions of individual plastic pieces estimated to be distributed throughout the world’s oceans.

“This plastic causes significant ecological and socioeconomic disruption as it accumulates in oceanic gyres, coastal habitats, and is ingested by fish, sea birds, and marine mammals.
“Micro-organisms rapidly colonise the surface of plastic pollution when it enters the environment, and their complex ecological interactions can shape the fate of plastic in marine systems.
“Understanding the function and ecology of micro-organisms colonising plastic pollution is therefore vital to adequately assess the risks of marine plastic pollution and to pave the way for biodiscovery beyond plastic biodegradation.
“Our study addresses a critical gap in our understanding of the ecological roles of the micro-organisms colonising marine plastic pollution.
“Few studies have determined which metabolic pathways are expressed by these micro-organisms, especially within colder climates.
“Our approach used state-of-the-art comparative metaproteomics and multi-omics to resolve not only which micro-organisms were present on marine plastic pollution, but also which micro-organisms were active.
“This is important because some micro-organisms colonising plastic pollution are known to degrade hydrocarbons and other pollutants.”
Sign up for our free indy100 weekly newsletter
How to join the indy100's free WhatsApp channel
Have your say in our news democracy. Click the upvote icon at the top of the page to help raise this article through the indy100 rankings
Top 100
The Conversation (0)












